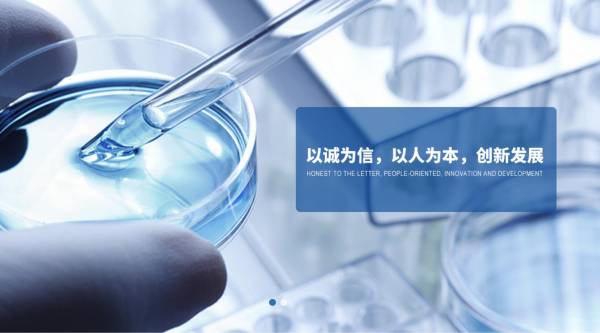

常州市*陽科技有限公司關鍵詞排名專注一站式品牌營銷整合推廣
日期 : 2020-09-25 20:06:01
常州市*陽科技有限公司選用我司企業化工原料行業的網站優化產品,其SEO關鍵詞有 江蘇農藥中間體,聚氨酯催化劑,醫藥中間體,常州甘氨酸甲酯鹽酸鹽廠家。其特點是用很合適的展示方式、展示效果、站點框架,把客戶及其用戶很關心的問題突出表現;并以簡潔明朗的設計風格,清晰展現公司水平實力,確保一秒抓住目標用戶眼球,給用戶留下良好的第一印象。常州市*陽科技有限公司成立于2002年,是經常州市市場監督管理局審核的有資質的公司,其統一社會信用代碼:913204131374**42XJ 。公司地址:中國·江蘇省常州市金壇區河頭興華路48號。

常州市*陽科技有限公司(原金壇市華陽化工廠)建于1992年春,地處常州西郊,地理位置優越,交通便利。是專業生產以聚氨酯催化劑系列、染料、醫藥、農藥中間體為主的企業,產品出口及銷往國內20多個省、市、自治區,為大型骨干集團企業指定配套產品,現有職工120余名,占地面積30000平方米,建筑面積3200平方米,固定資產5000余萬元。
企業基礎管理工作扎實,設備先進,產品檢測儀器齊全,并于大專院校、科研單位常年技術合作,技術力量雄厚,并通過ISO9001:2000國際質量體系認證。連續普升為市、省先進企業、“重合同能守信用單位”、獲得“省優質產品”稱號。

我們公司與常州市*陽科技有限公司合作中,對這個公司所經營的化工原料這個行業提供了搜索引擎優化推廣,同時讓我們積累到更多的經驗,與常州市*陽科技有限公司這個公司建立了友好的合作伙伴的關系,也提高了海洋網絡在同行業的知名度,提高了常州市*陽科技有限公司在同行業的知名度,發展越來越好。
我們公司不僅提供SEO優化推廣,百度快照排名,搜索引擎優化推廣,快速排名,關鍵詞搜索排名,SEO網站優化,網站建設制作設計,而且利用互聯網營銷手法,多平臺,多樣化進行品牌內容鋪設,營造企業正面形象。資深的項目團隊和完善的售后體系。我司誠摯為您服務,歡迎您的到來。

常州市*陽科技有限公司(原金壇市華陽化工廠)建于1992年春,地處常州西郊,地理位置優越,交通便利。是專業生產以聚氨酯催化劑系列、染料、醫藥、農藥中間體為主的企業,產品出口及銷往國內20多個省、市、自治區,為大型骨干集團企業指定配套產品,現有職工120余名,占地面積30000平方米,建筑面積3200平方米,固定資產5000余萬元。
企業基礎管理工作扎實,設備先進,產品檢測儀器齊全,并于大專院校、科研單位常年技術合作,技術力量雄厚,并通過ISO9001:2000國際質量體系認證。連續普升為市、省先進企業、“重合同能守信用單位”、獲得“省優質產品”稱號。
我們公司與常州市*陽科技有限公司合作中,對這個公司所經營的化工原料這個行業提供了搜索引擎優化推廣,同時讓我們積累到更多的經驗,與常州市*陽科技有限公司這個公司建立了友好的合作伙伴的關系,也提高了海洋網絡在同行業的知名度,提高了常州市*陽科技有限公司在同行業的知名度,發展越來越好。
我們公司不僅提供SEO優化推廣,百度快照排名,搜索引擎優化推廣,快速排名,關鍵詞搜索排名,SEO網站優化,網站建設制作設計,而且利用互聯網營銷手法,多平臺,多樣化進行品牌內容鋪設,營造企業正面形象。資深的項目團隊和完善的售后體系。我司誠摯為您服務,歡迎您的到來。
相關文章
精彩導讀
熱門資訊